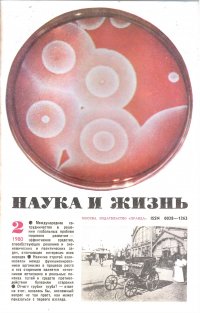

18+
На сайте представлено только описание и выходные данные книги «Журнал "Наука и жизнь" №2 1980 нет». Сайт не является распространителем книги. Сайт не предоставляет возможности купить, читать онлайн или скачать бесплатно книгу «Журнал "Наука и жизнь" №2 1980 нет». Сайт предназначен для лиц старше 18 лет. Если вам не исполнилось 18 лет - незамедлительно покиньте сайт. Оставаясь на сайте вы подтверждаете, что вам исполнилось 18 лет.
Незаконное потребление наркотических средств, психотропных веществ, их аналогов причиняет вред здоровью, их незаконный оборот запрещен и влечет установленную законодательством ответственность
Быстрая доставка. Простой возврат до 60 дней.
| Полное название книги | нет Журнал "Наука и жизнь" №2 1980 |
| Тип | Книга |
| Автор | нет |
| Категории | Художественная литература, Книги |
| ISBN | |
| Возрастное ограничение | 18 |
| Издательство | Правда |
| Год | 1980 |
| Название транслитом | zhurnal-nauka-i-zhizn-2-1980-net |
| Просмотров | 0 |
| Рейтинг izbe.ru | 0,0 |

Мари Мур

Брук Лин

Конкордия Антарова

Дэниел Киз

Абрахам Вергезе

Аида Синицына

Вадим Зеланд

Сергей Лукьяненко

Роберт Грин

Виктор Дашкевич

Роман Прокофьев

Пауло Коэльо